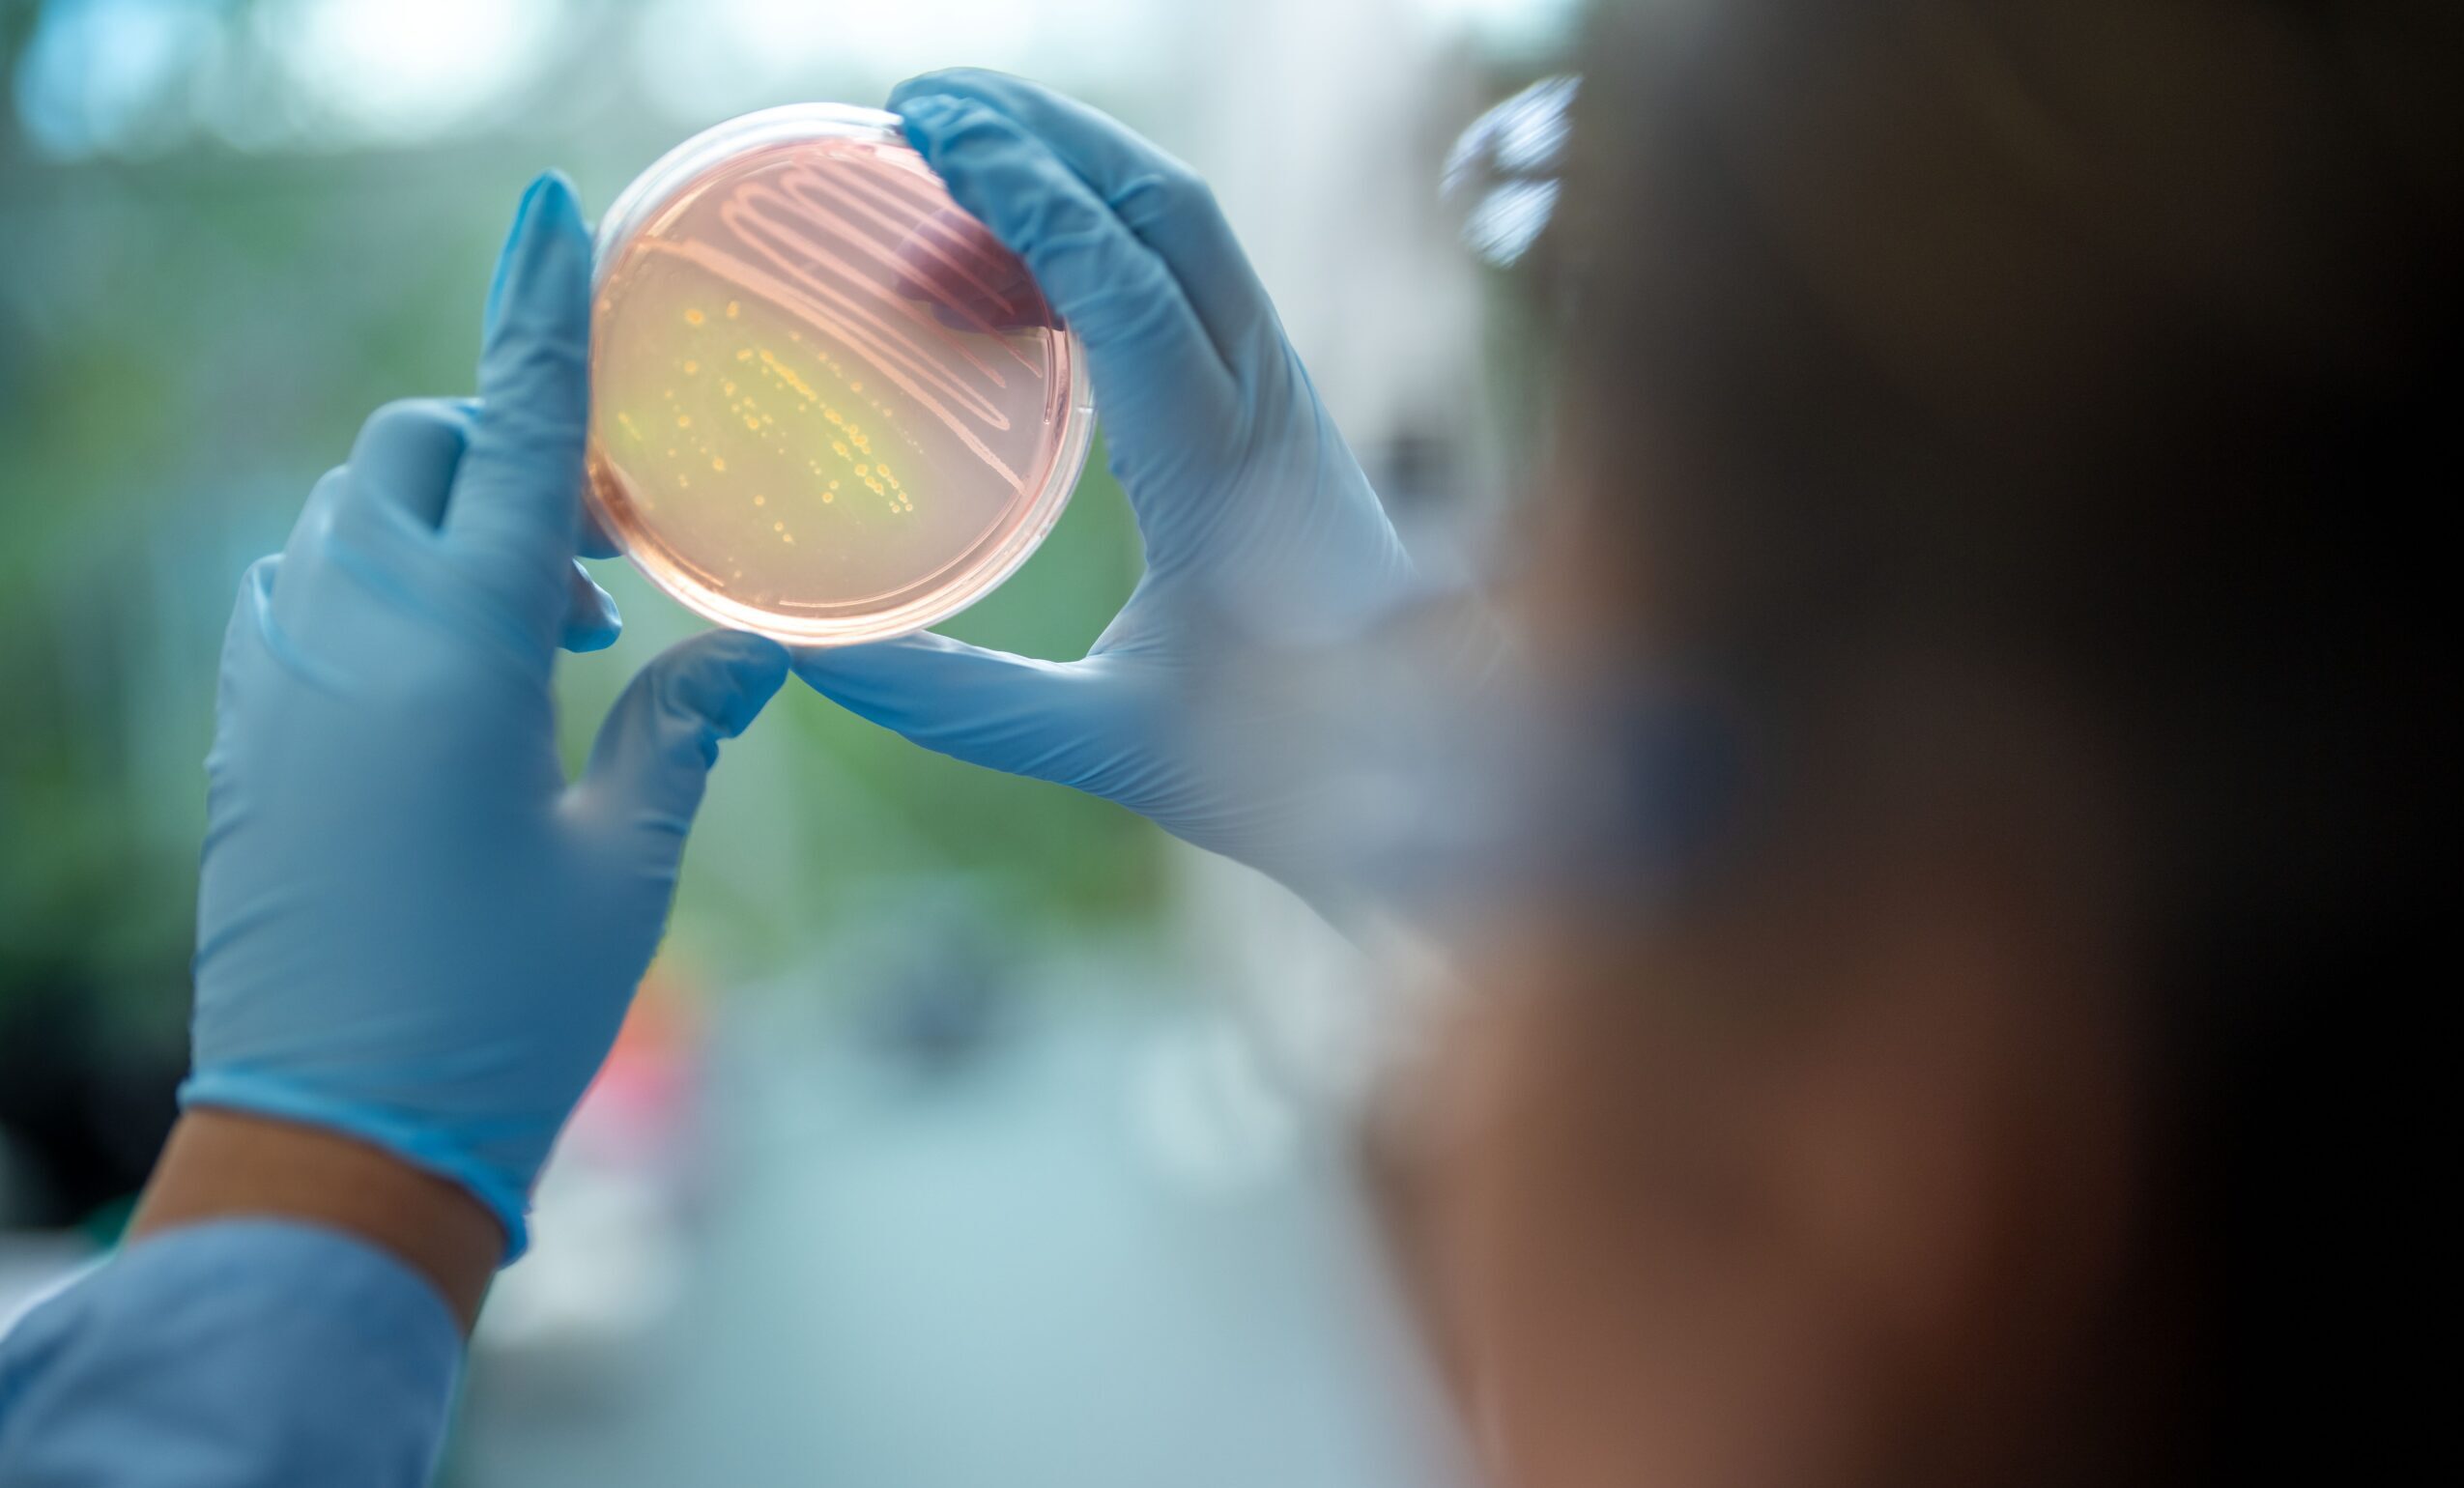

Feature
Building Bridges of Opportunity
North Park professors work to strengthen bonds with other institutions, paving a path toward success for students.
By Ellen Almer BA ’94
In 2022, North Park University (NPU) Professor of Biology Dr. Timothy Lin invited a colleague from Northwestern University’s Center for Synthetic Biology to talk to his students about careers in biotechnology and solving societal issues with synthetic biology. He never imagined that meeting would evolve into a thriving academic partnership between the two schools.
“She was very impressed by the caliber of the questions our students asked,” Lin said of Dr. Danielle Tullman-Ercek, director of Northwestern’s Master of Science in Biotechnology program and professor of chemical and biological engineering. She was so impressed, in fact, that she invited one of the students to work in her lab that summer. It was the beginning of what has proven to be a fruitful partnership.
We wanted to provide the opportunity to North Park undergraduate students … to research at Northwestern to give them a feel for what research at an R1 institution is like.
—Danielle Tullman-Ercek
This past spring, North Park and Northwestern began a program in which up to two NPU molecular biology and biotechnology (MBBT) majors—selected from a pool of about 10 MBBT majors eligible to apply—will intern in Tullman-Ercek’s lab each year, assisting in cutting-edge research and earning credit toward graduation. The work at Northwestern’s Center for Synthetic Biology touches on everything from advancements in medical therapies to consumer products and environmental testing.
“We wanted to provide the opportunity to North Park undergraduate students—particularly given that many are local to Chicago—to research at Northwestern to give them a feel for what research at an R1 institution is like,” said Tullman-Ercek. The R1 designation refers to universities that spend at least $50 million on research and development and award at least 70 doctorates per year.
For Lin, it was an opportunity to let NPU students shine in a bigger arena. “As a professor, you train students to excel and identify ones who especially make North Park shine,” Lin said. “Then, you grab the opportunities that come your way to make things happen for them and the university.”
In recent years, North Park has taken advantage of its location in Chicago to cultivate partnerships for other medical field programs as well. One such example is a unique alliance between NPU and Roosevelt University’s College of Science, Health and Pharmacy, in which first-year North Park students can earn a Bachelor of Arts in Biochemistry and a Doctor of Pharmacy in a total of six years—an entire year sooner than the traditional seven.
Our connections with various clinical locations throughout the city … are compelling to those pursuing careers in athletic training.
—Andrew Lundgren
Another partnership is North Park’s affiliation agreement with Illinois College. Through this agreement, North Park guarantees admission each academic year to two Illinois College graduates into its Master of Science in Athletic Training (MSAT) program. Illinois College faculty are responsible for recommending candidates for these two reserved spots. Once nominated, the selected students must still complete the standard application process required of all MSAT applicants.
“Our location in Chicago is definitely a bonus,” said Andrew Lundgren MA ’01, North Park’s athletic training program director and an associate professor of athletic training. “Our connections with various clinical locations throughout the city and professional sports teams are compelling to those pursuing careers in athletic training.”
Collaborating with reputable institutions enables NPU to attract highly qualified applicants, said Lundgren, who is currently exploring additional partnership opportunities. Also in the School of Nursing and Health Sciences, North Park places its nursing majors in magnet-designated hospitals for their clinical rotations. The Magnet Recognition Program from the American Nurses Credentialing Center acknowledges healthcare organizations with excellent nurses and outstanding work environments. It is the gold standard for nursing practice and patient care. North Park’s partnerships with such hospitals throughout Chicagoland—like Ann & Robert H. Lurie Children’s Hospital of Chicago, Endeavor Health Swedish Hospital, and Northwestern Memorial Hospital—set its students up for career success following graduation.
Beyond the STEM field, NPU partners with local community colleges—including Triton College, the College of DuPage, and the College of Lake County—to guarantee its students transfer admission to North Park. As part of the program, North Park’s admissions counselors assist in transferring students’ credits to ensure they complete their bachelor’s degrees as quickly as possible.
North Park’s partnerships with such hospitals throughout Chicagoland—like Ann & Robert H. Lurie Children’s Hospital of Chicago, Endeavor Health Swedish Hospital, and Northwestern Memorial Hospital—set its students up for career success following graduation.
“The partnership is mutually beneficial,” said Malcolm Parker MOL ’22, North Park’s associate director of transfer admissions. “Transfer agreements remove doubts and provide clarity for transfer students who want to earn a bachelor’s degree. Our goal at North Park is to open doors so our transfer students have a clear pathway to pursue lives of significance and service.”
After more than 130 years as a fixture in Chicago, NPU has built a reputation for excellence in preparing students for lives of significance and service. The partnerships that have grown from that reputation have cemented North Park as one of the leading educational institutions in the city.
SHARE WITH FRIENDS